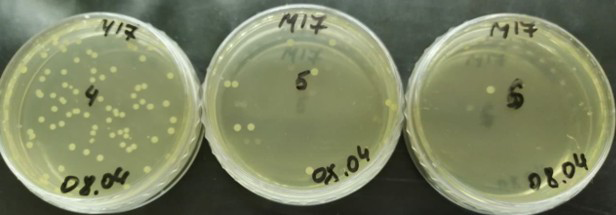
1

Infection Wake-up call: Scientists have exposed inactive pathogens in food
- Статьи
- Science and technology
- Infection Wake-up call: Scientists have exposed inactive pathogens in food

Russian scientists have proposed a new method for detecting "dormant" pathogens in food. These are bacteria that become inactive under unfavorable conditions and therefore escape standard sanitary control. Experts have identified the optimal conditions that awaken such microorganisms, returning them to a detectable form. Unlike traditional methods, it is proposed to use relatively poor nutrient media based on fish proteins rather than enriched ones. The work lays the foundation for creating more sensitive and accurate food safety control systems, experts believe.
How to awaken an invisible threat
Scientists from the Russian Biotechnological University (Rosbiotech) have developed a technique that makes it possible to find dangerous microbes in food that are invisible to routine sanitary inspections. The development paves the way to creating more reliable food quality control systems than traditional ones.
As the experts explained, we are talking about microorganisms capable of falling into a so—called viable, but uncultivated state - a kind of hibernation. Bacteria enter it in response to unfavorable factors for them. Such as heating, salting, adding preservatives, refrigerating, and other types of food processing. In this state, microbes do not multiply, but they remain alive and can wake up when they find themselves in favorable conditions.
— Therefore, the detection of uncultivated microorganisms in various substrates that can cause infectious diseases is one of the essential scientific and practical tasks. It is important to understand what causes bacteria to "hibernate" and what can "wake them up." The answers to these questions are important for medicine, sanitary control and agriculture," Rumiya Valitova, the author of the study and a graduate student at Rosbiotech University, told Izvestia.
According to her, the scientific work focused on the study of the most dangerous pathogens — E. coli, Salmonella and Staphylococcus aureus. They were studied under stressful conditions typical of food production. In particular, scientists have found that with salting and nutrient deficiency, these microorganisms become inactive for 56 days.
— One of the unexpected results was the identification of the conditions for the release of bacteria from the state of "hibernation". Strangely enough, this requires not a nutrient—rich environment, as previously thought, but a rather poor composition based on easily digestible fish proteins," the specialist noted.
For example, taking samples from the meat processing plant's equipment and samples of frozen sausage, scientists using standard analysis did not find dangerous microbes in them, Rumiya Valitova said. However, the new technique, on the contrary, made it possible to identify a significant number of "dormant" bacteria.
Is it worth reviewing the methods of product quality control
According to her, the results of the study cast doubt on the effectiveness of traditional methods of diagnosing dangerous pathogens and indicate the need to review current laboratory practices. At the same time, the proposed approach forms the basis for creating more sensitive technologies for detecting hidden but viable microorganisms.

Based on the results of the work, recommendations have been prepared for the food industry. They can become a tool for improving food safety and reducing the risks of foodborne diseases, Rumiya Valitova added.
— The dormancy of bacteria is a common evolutionary survival strategy. In this form, the pathogen waits out an unfavorable period, and then, when conditions improve, it returns to an active state. A classic example is Vibrio cholerae in an aquatic environment. It is the causative agent of a dangerous disease — cholera. This bacterium also has the ability to enter a viable uncultivated state, which complicates its detection," said Sergey Kharitonov, a molecular biologist and researcher at Lomonosov Moscow State University.
The significance of the work, according to him, is that scientists have investigated a wide range of factors that make it possible to awaken and identify potentially dangerous microorganisms. They also managed to find the conditions under which pathogens move from a latent state to a form that can be detected. The expert added that existing methods for detecting such "dormant" bacteria are based on DNA analysis, which requires expensive reagents and sophisticated equipment. In this context, the developed cost-effective approach can be successfully implemented in the daily practice of quality control.
— There are a number of bacteria that are in suspended animation outside the human body and come to life as soon as they enter the body. But this does not mean that specialists miss any risks if they do not detect such microorganisms," said Natalia Efimochkina, Deputy Director for Scientific Work at FITZ Nutrition and Biotechnology, Doctor of Biological Sciences.
There are safety criteria for all microorganisms that pose risks to human life and health. They are supported by epidemiological and scientific research, she said. That is, dangerous pathogens that can cause diseases are under the constant attention of scientists. Such risk factors are identified 24/7. At the same time, microorganisms are constantly changing. Thus, they survive by "learning" in response to human exposure and other negative factors for them. That's why scientists always keep their finger on the pulse and improve methods for detecting pathogens in food, she added.
Переведено сервисом «Яндекс Переводчик»
